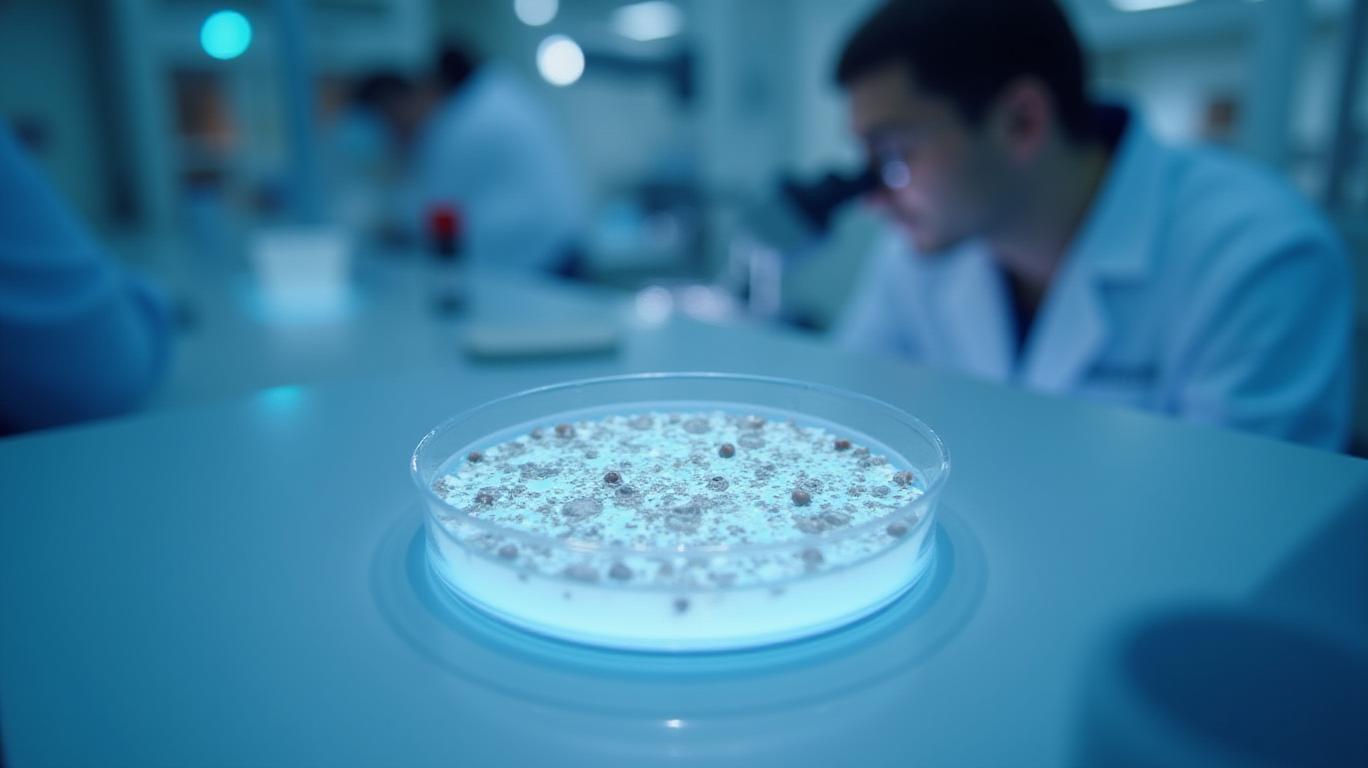

Human Dental Stem Cells Can Be Transformed into Excitable Neuronal Cells for Neurodegenerative Disease Treatment.
ByAinvest
Monday, Apr 7, 2025 10:42 pm ET1min read
GAB--
Researchers at the University of the Basque Country have successfully transformed human dental stem cells into excitable neuronal cells, opening up new avenues for the study of neurodegenerative diseases and the development of future autologous transplants. The study, published in Stem Cell Research & Therapy, highlights the potential of these easily accessible cells for nerve tissue engineering. The differentiated cells are capable of synthesizing inhibitory neurotransmitters, such as GABA, and have electrophysiological activity similar to neurons. This breakthrough could lead to advances in cell therapy for treating neurodegenerative diseases.
Stay ahead of the market.
Get curated U.S. market news, insights and key dates delivered to your inbox.
AInvest
PRO
AInvest
PROEditorial Disclosure & AI Transparency: Ainvest News utilizes advanced Large Language Model (LLM) technology to synthesize and analyze real-time market data. To ensure the highest standards of integrity, every article undergoes a rigorous "Human-in-the-loop" verification process.
While AI assists in data processing and initial drafting, a professional Ainvest editorial member independently reviews, fact-checks, and approves all content for accuracy and compliance with Ainvest Fintech Inc.’s editorial standards. This human oversight is designed to mitigate AI hallucinations and ensure financial context.
Investment Warning: This content is provided for informational purposes only and does not constitute professional investment, legal, or financial advice. Markets involve inherent risks. Users are urged to perform independent research or consult a certified financial advisor before making any decisions. Ainvest Fintech Inc. disclaims all liability for actions taken based on this information. Found an error?Report an Issue

Comments
No comments yet